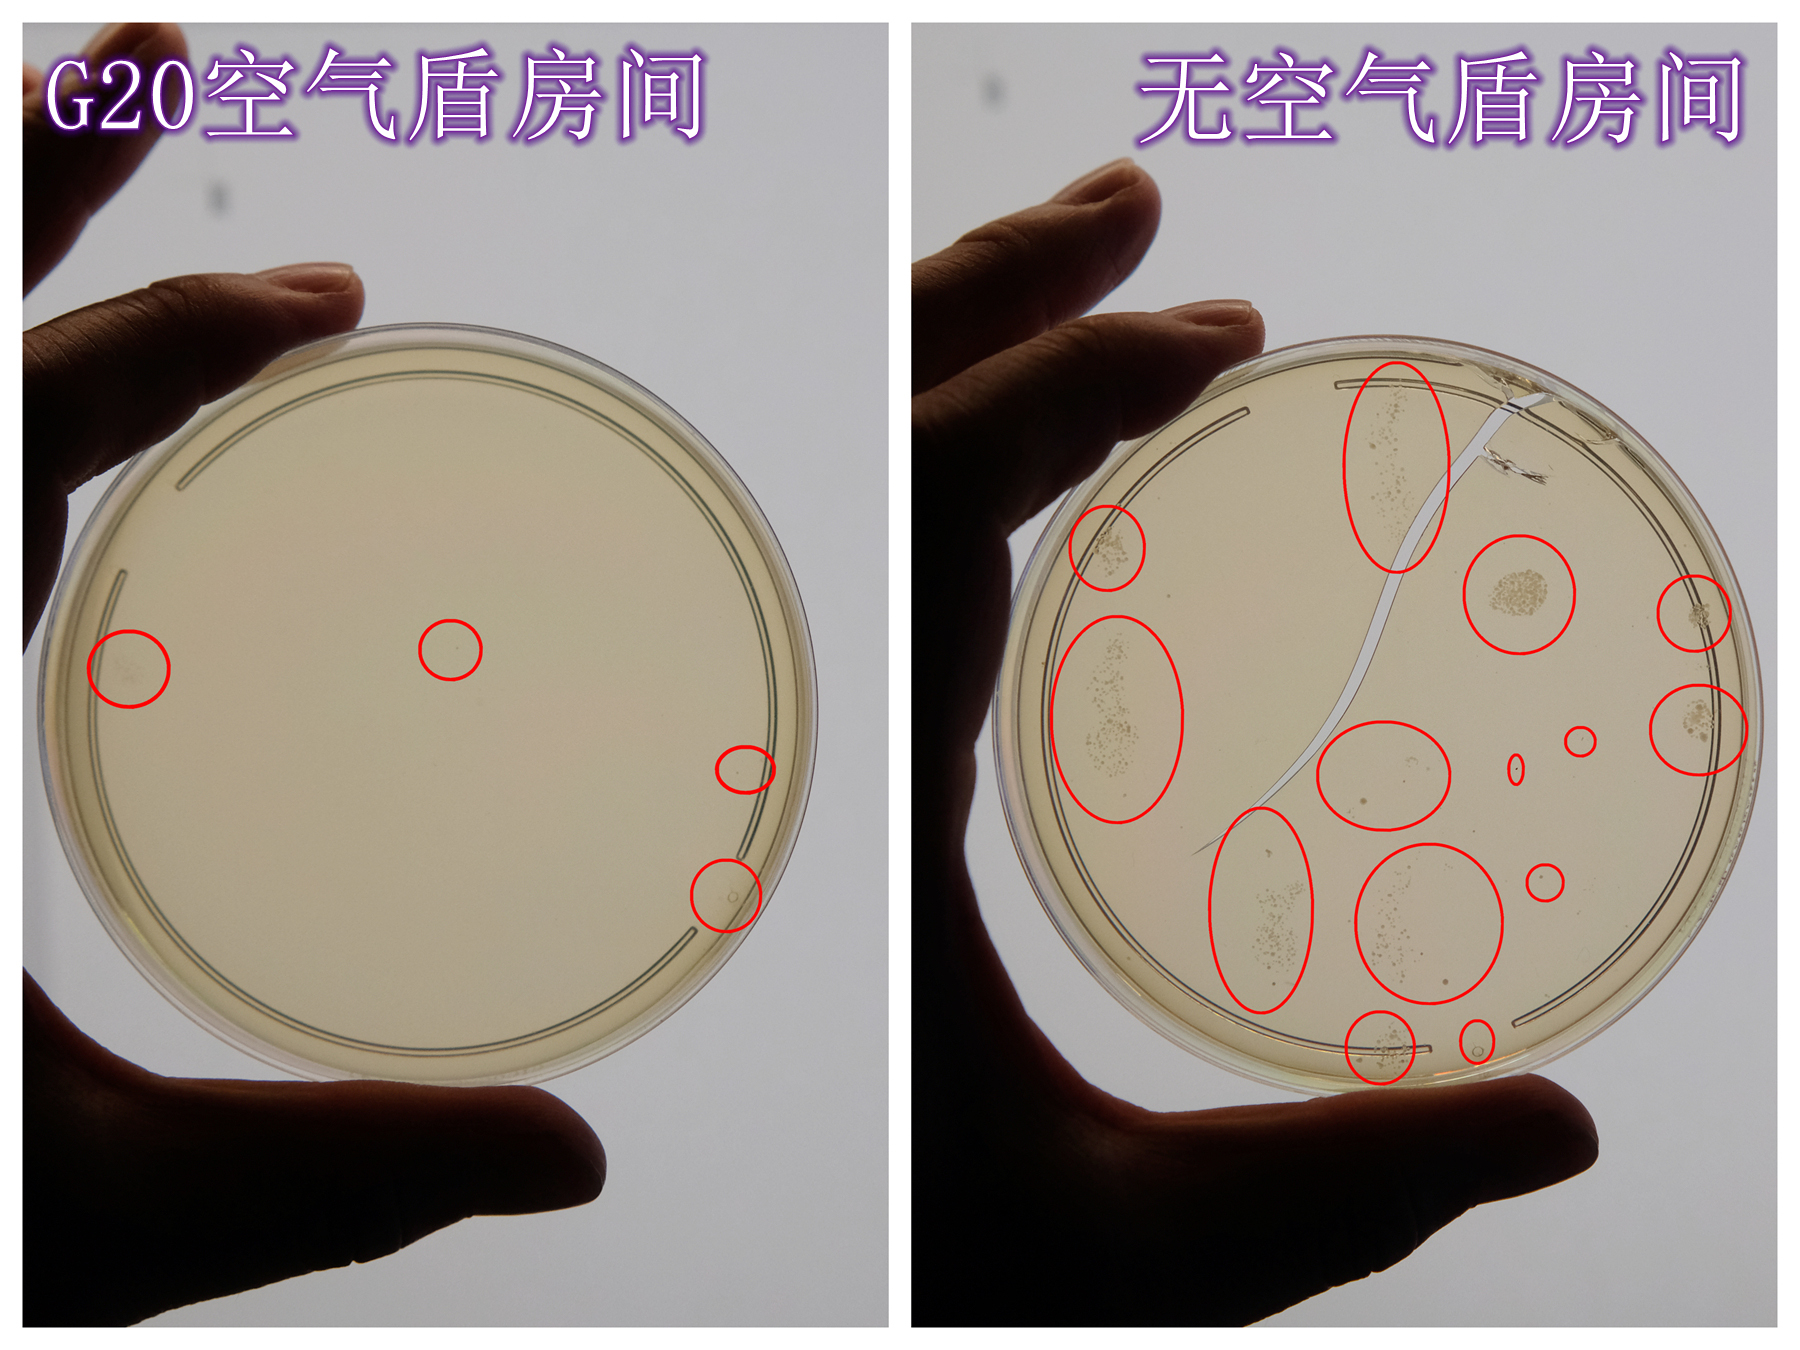

家里的房子终于快装修好了,欣喜之余,家人朋友的呼吸健康问题也需要要重视起来。因为新居入住,各种装修材料、橱柜板材还有新家具,都无可避免的会散发出诸如甲醛、甲苯、氨气等有毒有害气体,对我们的健康造成不可估量的损害。其中甲醛还会持续挥发,在日常生活中的甲醛有可能在3-15年里一直长期缓释,所以除了必要的通风,长期持续除醛除各种有害气体就变得非常有必要了。
其实家里出了除了上面说的这些家具家居释放有害气体,我这个过敏性老鼻炎也对现在城市里的各种空气污染也十分敏感,例如汽车尾气、花粉、还有飘来的雾霾,都会导致我一天不停的打喷嚏,吃抗过敏药都没啥用,非常的痛苦。
有了空气净化器,我就会舒服很多,是我绝对的刚需。我这些年也用过的空气净化器也能说不少了,积攒下了一些选购和使用的小经验,空气净化器也在不断的发展,从最初单纯的被动吸附进化到了能够主动分离、分解和过滤各种空气中的气态、固态污染物。因为入手了一台全能高效的空气净化器,我最近也是做了很多功课,就在这里结合我选的舒乐氏全效空气净化器G20来分享给有大家,希望能够抛砖引玉,给同样对高性能空气净化器感兴趣的小伙伴一些帮助和启发。

新居入住,有持续除醛除苯需求时;
有婴儿、老人,病人及呼吸系统敏感人群时;
室外空气污染,有雾霾或者是沿街居住粉尘多时;
家有萌宠,有特有气味和掉毛现象时;
还有其他感觉不舒服的时候……我个人是除非空气质量是优,其他时间都是家中常开空气净化器。

CADR、除醛净化器技术、CCM、覆盖面积、噪声、权威认证,这几点是我最重视的空气净化器的性能指标。

CADR是每小时可净化空气量的缩写,是衡量空气净化速度的关键指标。一台空气净化器的CADR数值越大,就能在越短的时间内净化室内的空气。CADR分为颗粒物与甲醛两种,像我一样是新装修的话,除了固态颗粒物CADR值,还需要重点关注甲醛的CADR数值。配合四向双进双出的飓风风道,能够加速净化空气,实测颗粒物CADR最大可达1613.5m³/h,甲醛CADR最大可达1156.7m³/h。在这个级别来看是非常的优秀了。舒乐氏全效空气净化器G20采用了进口分解式紫晶除醛,能够实现1分钟全屋空气焕新,24小时千次循环,净化效率提升189%,可将室内甲醛疾速降至0.01mg/m³,大幅优于室内甲醛浓度国家标准阀值的0.08mg/m³。
除醛净化技术舒乐氏G20空气净化器搭载了新一代双风机净化系统配置。

前后进风口都配备了初效滤网与多功能复合滤网。

前后进风,左右出风,无死角净化室内空气。

舒乐氏全效空气净化器G20采用TCF猎醛因子+进口紫晶+MAC催化粒子实现三重分解甲醛。MOFS分离舱拥有多孔结构与超高比表面积,通过孔径筛分效应和表面官能团的共同左右,形成立体多维结构精准且迅速的靶向捕抓动态TVOC(总挥发性有机化合物),无论是甲醛还是其他有害气体TVOC、甲苯、苯,都能去除的干干净净!

CCM是表示空气净化器滤网能够净化的污染物总质量,单位为毫克(mg)。CCM值越高,说明空气净化器的持续净化能力越强,滤网的使用寿命也越长,我们日常的耗材使用成本也会更低。
我们选空气净化器的时候,要注意CCM值与CADR值的平衡,有些产品拥有较高的CADR值,但CCM值较低,那么滤网就需要频繁更换,使用成本较高。我们要考虑CADR和CCM都比较优秀的产品,舒乐氏全效空气净化器G20的颗粒物值达到了55884mg,远超国标,达到新国标GB/T18801规定的最高级P4(12000mg)的4倍以上,甲醛CCM值也高达12000mg,除醛含量远超国标最高级别的F4(1500mg以上),相当于新国标的8倍,有着超长的寿命。

一般来说,我们是按照空气净化器的CADR值来选择。CADR值应至少为房间体积的2-3倍,选购时可参考以下公式:适用面积 = (0.07~0.12) × CADR值(我个人是推荐能大就不选小),在空气污染比较严重的情况下,例如新装修好的房间,我们尽量选高CADR的产品。
舒乐氏全效空气净化器G20计算下来,能覆盖的标准面积达到了190㎡,就算是别墅、大平层也没问题,对于我140㎡建筑面积的小家来说,可以说是轻松Hold住了。

现在空气净化器的CADR值越来越高,内部风扇就要提高转速,这样噪音就难免随之升高。一台真正有效的空气净化器不仅要净化效率和能力强,噪音也要越低越好。舒乐氏全效空气净化器G20普通工作噪音低至34.1分贝,在睡眠模式下更是低于我家的底噪30分贝,已经测不出G20的噪音值了。如此上佳的静音表现,24小时开机也完全不会影响到我们的工作和睡眠,就算是我怕吵的老婆大人也说听不到G20的噪音。

即使是最快5档风速,噪音也不超过60分贝,家人都表示完全不会被吵到。

对于无法验证各种性能指标的普通消费者来说,如何识别市场上的“李逵与李鬼”呢?我想各种权威认证就能为我们消费者很好的进行保证。舒乐氏全效空气净化器G20拥有6大权威认证,让我用的放心!

舒乐氏获得了各种国内外权威奖项,让我选起来更有底气!

对于空气净化器的净化效果,我想大家和我一样,最看重的是甲醛和TVOC两个指标。为了验证新家空气是否合格,我跟着网上的范例买了几个小工具,既能让我放心住新家,也能通过简单的测试来看看G20的净化效果是不是真的那么牛。
甲醛气态污染:测试甲醛净化效果,我买了一瓶福尔马林中性固定液,也就是10%的甲醛溶液当做污染源。

把它放在关闭门窗的小房间里过24小时,进风口空气甲醛浓度稳定在0.12mg/m³左右、甲醛检测仪显示“轻度污染”后,开始用自动模式进行测试。

在保留污染源,模拟日常甲醛的正常挥发的情况下,舒乐氏全效空气净化器G20在10分钟内就把甲醛浓度降到了0.04mg/m³以内,出风口更是只有0.005 mg/m³,净化速度和效果确实没的说,顶级的表现。

TVOC是总挥发性有机化合物的缩写,在我们家庭装修中,TVOC主要来自油漆,涂料和胶粘剂的挥发,对人体健康的影响同样不小。我在室内喷洒花露水来模拟高浓度TVOC:果不其然,舒乐氏全效空气净化器G20迅速检测到了空气的异常,状态“飚红”、马上自动加大风量来进行净化。3分钟后,室内空气重现“蓝标”,TVOC数值从3.000mg/m³直落0.519mg/m³,效率真是杠杠的。

除了过滤分解,舒乐氏全效空气净化器G20还具备空气盾多重消毒能力,为家中的易敏、体弱者,增加一份保障。我琼脂平板培养基进行了微生物细菌总数的大概统计,一个琼脂平板培养基放在24小时开着G20的主卧,作为对比的另一个放次卧。

经过1天后,两个培养基的差异,在我看来还是比较明显的,在G20的作用下,主卧的培养基菌落要明显少于次卧的对照组。虽然我这个做法不够科学、严谨,但也能从一定程度上证明G20的空气盾确实有效。
对于我家的日常来说,只需要开启最小的1档风速就能在很短的时间净化到理想效果,经过舒乐氏全效空气净化器G20过滤后的PM2.5数值只有0001,而我的空气监测仪更是显示PM2.5为0,充分说明了G20的极致净化能力。

舒乐氏全效空气净化器G20采用触控操作,按键都在机身顶部,电源开关和风速开关一左一右,边上有PM2.5/PM10、等离子、更换滤网、灯光/睡眠、智能、UVC、定时、童锁、甲醛/TVOC选择开关。

舒乐氏全效空气净化器G20的IMAX级彩屏显示效果也十分出色,各种参数、监控数据都显示的美观而清晰。

除了传统的按键操控,舒乐氏全效空气净化器G20自然也是支持手机APP全功能远程超控,我们在外面的时候或者躺平不想动的时候,用起来也是如臂使指。

舒乐氏全效空气净化器G20采用双风机四进四出风道设计,强悍的过滤能力和过滤量非常适合大面积客厅或者大平层的全屋覆盖净化;在净化能力上,无论是烟雾净化还是除醛净化,均有亮眼发挥,而且机器颜值高、做工优良,各种细节都很到位,可以说是物有所值的高性能全效空气净化器。我用下来感到十分满意,也推荐给大家!